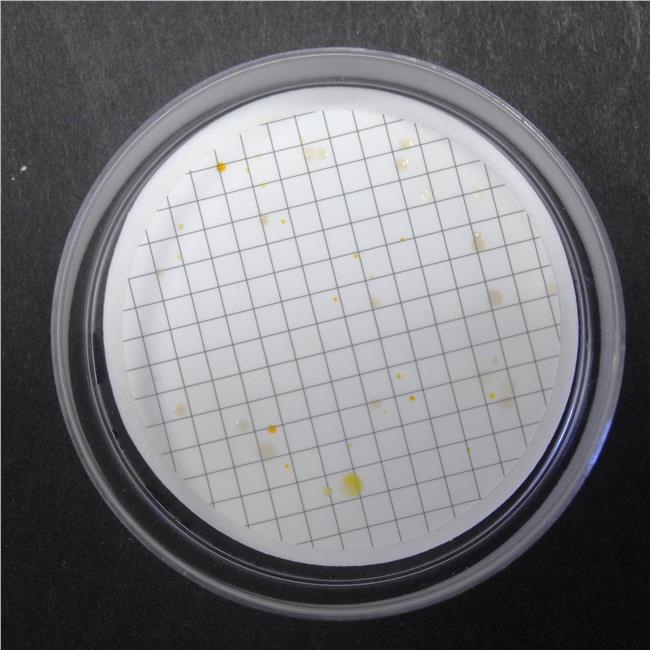

Easy DryTM are absorbent pads saturated with a sterile, dehydrated culture medium. Each pad is pre-plated in a Petri dish and is immediately ready to use after pouring sterile distilled or deionized water on it. Easy DryTM are optimal for the examination of large sample volumes by the membrane filter method.
Easy DryTM R2A is a low nutrient medium used for microbial monitoring of treated potable water.
This medium is recommended by the European Pharmacopoeia (EP) and the American Public Health Association (APHA) for examination of water.
PREPARATION
1.
Cut open a bag and remove the number of Easy Dry plates needed.
2.
Moisten the pad contained
in the Petri dish with 2.2 ml of sterile distilled or deionized water.
3.
Wait 5 minutes before
using.
TEST PROCEDURE
INTERPRETING RESULTS
Report the count as CFU/ml of sample allowing for dilution factors and report incubation time and temperature.
APPEARANCE OF THE MEDIUM
Appearance of the Medium: Whitish pad.
STORAGE
Store at 10-25°C away from light. Do not
use the product beyond its expiry date on the label or if product shows any
evidence of contamination or any sign of deterioration.
SHELF LIFE
2 years.